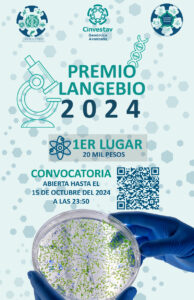
Langebio, Premio, Genética, Biotecnológica, Cinvestav,

Ciudad de México, 3 de octubre de 2024.-
Cumple 12 años de incentivar el desarrollo de proyectos nacionales, a nivel doctorado, relacionados con el aprovechamiento sustentable de la biodiversidad.
La convocatoria nacional del Premio Langebio 2024, la cual está abierta y es patrocinada por la Unidad de Genómica Avanzada (UGA) del Cinvestav, busca reconocer a las mejores tesis de doctorado del país en el área de la investigación genética. Esto con el fin de impulsar la formación de personal científico de alta calidad y promover el desarrollo de proyectos con impacto a nivel nacional e internacional.
La convocatoria nacional del Premio Langebio 2024, la cual está abierta y es patrocinada por la Unidad de Genómica Avanzada (UGA) del Cinvestav, busca reconocer a las mejores tesis de doctorado del país en el área de la investigación genética. Esto con el fin de impulsar la formación de personal científico de alta calidad y promover el desarrollo de proyectos con impacto a nivel nacional e internacional.
“Este galardón tiene una relevancia particular porque está centrado en la promoción de jóvenes talentos en el ámbito de la investigación genética y biotecnológica, lo cual lo convierte en una plataforma única para catapultar a las y los nuevos científicos enfocados en temas cruciales para México”, señaló Stewart Gillmor, investigador de la UGA-Langebio del Cinvestav e integrante del comité organizador y jurado del Premio.
Así, la idea inicial del Premio no solo era reconocer a las y los científicos en ascenso, sino también visibilizar el impacto del entonces Laboratorio Nacional de Genómica para la Biodiversidad (Langebio), ahora conocido como UGA-Langebio, una de las unidades más jóvenes del Cinvestav.
Los orígenes de este Premio se remontan a 2013, cuando se lanzó la primera convocatoria en el marco de los “Días Académicos”, evento que alberga alrededor de 200 participantes, en el que estudiantes de posgrado de la UGA-Langebio exponen sus investigaciones y se presentan ponencias nacionales e internacionales.
Respecto de las expectativas de la convocatoria actual, “esperamos contar con una cantidad considerable de aspirantes, superior a 30, y confiamos en recibir solicitudes que reflejen el talento científico emergente en el país”, dijo Stewart Gillmor.
Mientras que a largo plazo, agregó, buscamos consolidar este Premio como una herramienta clave para identificar a jóvenes investigadores destacados, tanto hombres como mujeres, ayudando así a construir una comunidad de investigación sólida en México, capaz de afrontar los retos globales desde una perspectiva científica avanzada.
Los participantes deberán haber realizado su doctorado en alguna institución mexicana y presentar un trabajo de investigación desarrollado en el país, en cualquiera de las siguientes cinco áreas: agrobiotecnología, biología celular y del desarrollo, biología computacional, biología estructural y de sistemas, ecología, evolución y biodiversidad.
La convocatoria estará abierta hasta el 15 de octubre del 2024, posteriormente el jurado, integrado por especialistas nacionales y del extranjero, así como estudiantes de doctorado, elegirán a tres finalistas, quienes serán dados a conocer el 30 de octubre y podrán asistir a la UGA el próximo 5 y 6 de diciembre para formar parte de los “Días Académicos”, en donde presentarán su investigación en inglés con el fin de tener la oportunidad de obtener 20 mil pesos mexicanos.
Para consultar la convocatoria del Premio Langebio 2024: https://portal.cinvestav.mx/uga-langebio/oferta-academica/convocatorias/premio-langebio-edici243n-2024
 UNIVERSIWEB Noticias locales, naciones e internacionales
UNIVERSIWEB Noticias locales, naciones e internacionales



